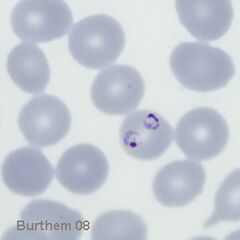

P.falciparum early trophozoites
Summary
At this stage we look for typical (and often frequent) delicate rings within red cells that have normal (or slightly crenated) appearance. Forms often seen in this species include accolé forms, double chromatin dot forms, and multiple parasites within infected red cells.
Fine ring form The small and delicate form of this species
Double chromatin dot form Two chromatin dots (sometimes known as "signet ring" form.
Multiple early trophozoites within a single erythrocyte, one having a double chromatin dot
Delicate and small early trophozoite form of Plasmodium falciparum
Two early forms of P.falciparum one with the characteristic double chromatin dot
Multiple early trophozoites within a single erythrocyte, one having a double chromatin dot